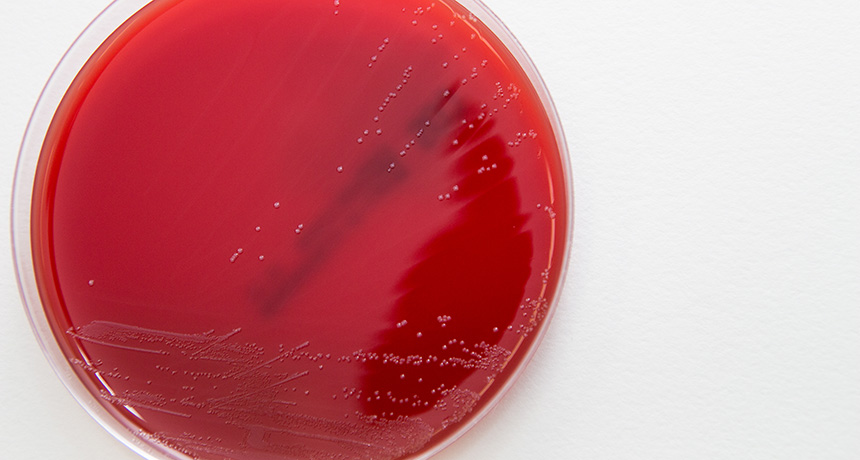
Streptococcus gallolyticus

GROWTH SPUR An intestinal bacterium called Streptococcus gallolyticus (white, growing in a petri dish) has previously been linked to colon cancer. Now researchers are getting clues about how the bacterium promotes tumor growth.
© Daniela Beckmann
GROWTH SPUR An intestinal bacterium called Streptococcus gallolyticus (white, growing in a petri dish) has previously been linked to colon cancer. Now researchers are getting clues about how the bacterium promotes tumor growth.
© Daniela Beckmann